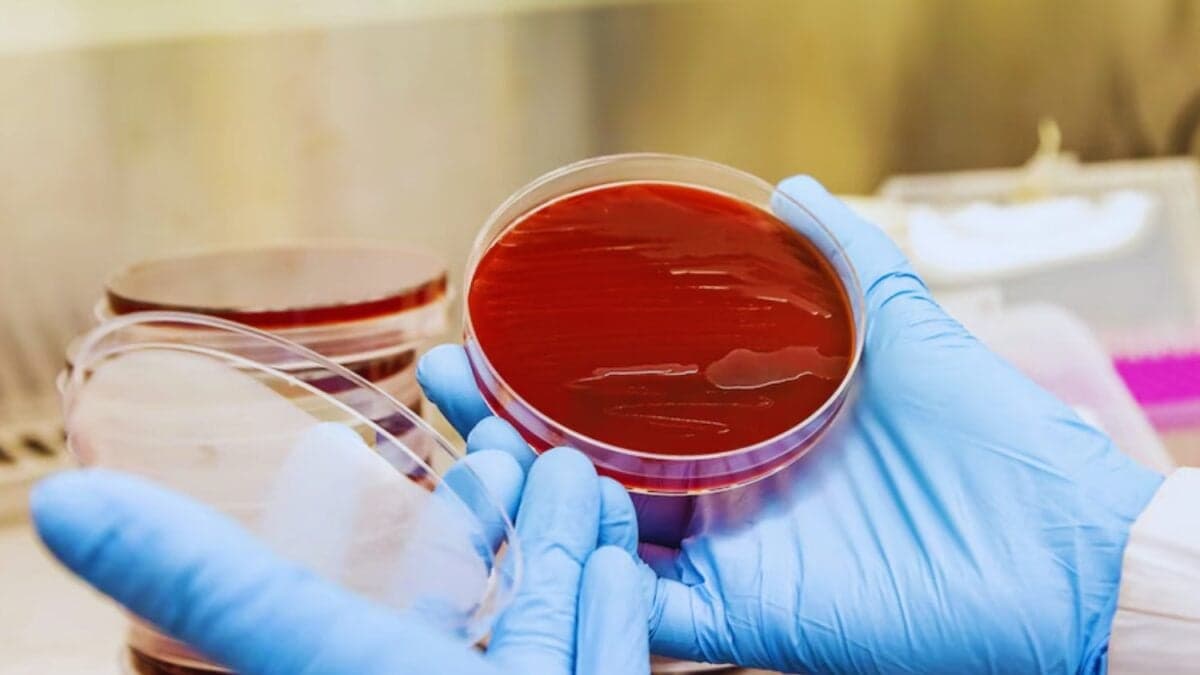
Un bot latinoamericano se adelanta al diagnóstico. Una inteligencia artificial que interpreta bacterias y promete cambiar la salud pública

Un bot latinoamericano se adelanta al diagnóstico. Una inteligencia artificial que interpreta bacterias y promete cambiar la salud pública
12 de septiembre de 2025

Durante décadas, los manuales técnicos en inglés y las bases de datos fragmentadas marcaron la diferencia entre un diagnóstico certero y uno incierto. En la Argentina, un equipo de científicos decidió cambiar esa historia. El resultado es Maldi-Bot, un sistema de inteligencia artificial que promete democratizar el acceso a la información microbiológica.
La necesidad de un asistente inmediato
El MALDI-TOF revolucionó la microbiología al analizar bacterias en minutos, pero su lectura seguía siendo un desafío. Muchas veces los resultados ambiguos o especies poco frecuentes quedaban sin respuesta rápida. Para laboratorios alejados de los grandes centros urbanos, la falta de guías accesibles en español complicaba aún más el panorama. Así surgió la idea de un asistente virtual capaz de resolver dudas en tiempo real, sin depender de manuales extensos ni de búsquedas poco confiables en internet.
Cómo funciona Maldi-Bot

El sistema corre en computadoras y celulares. Alimentado por bases de datos actualizadas y revisadas por expertos, interpreta consultas en lenguaje sencillo y devuelve recomendaciones claras, respaldadas por protocolos nacionales e internacionales. Si la identificación no es concluyente, sugiere pruebas moleculares adicionales o explica qué significa cada resultado. En las primeras pruebas, 18 profesionales de cinco laboratorios diferentes lo usaron durante seis semanas: la totalidad lo consideró fácil de manejar y el 80% abandonó manuales en papel.
Impacto y desafíos futuros
Maldi-Bot resolvió más del 80% de las consultas, lo que evidencia su potencial para agilizar diagnósticos y mejorar tratamientos a tiempo. También funciona como recurso educativo, ya que permite aprender sobre bacterias poco habituales. Sin embargo, aún queda un 20% de vacíos de información, sobre todo en especies nuevas. El equipo trabaja en ampliar la base de datos, lanzar una versión para hongos y traducir el sistema al inglés. La directora de ANLIS Malbrán, Claudia Perandones, destaca que esta innovación consolida a la Argentina como referente en inteligencia artificial aplicada a la salud pública.